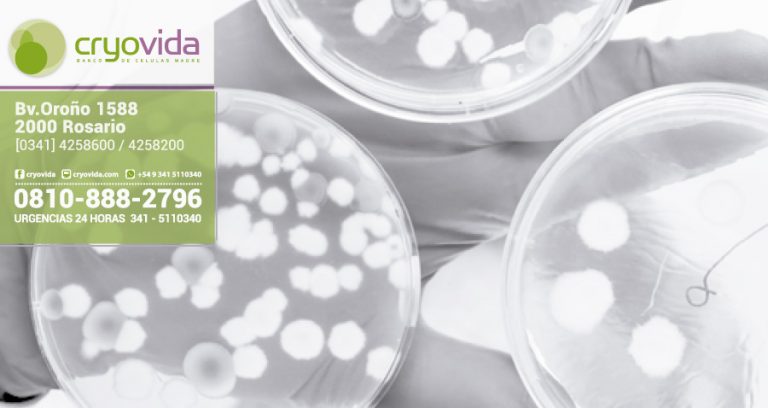
Antitumorales a bordo de células madre para atacar al cáncer

5 preguntas sobre la importancia del Cordón Umbilica
Las células madres funcionan y son una palpable realidad
Antitumorales a bordo de células madre para atacar al cáncer
¿Cómo surge el vínculo entre una madre y su hijo?
Los primeros paseos del bebé recién nacido
Identifican dos proteínas indispensables para preservar células madre de la piel
La fuerza de las proteínas en el embarazo
Células madre del propio paciente para curar la Enfermedad de Machado-Joseph
Células madre del propio paciente para curar la Enfermedad de Machado-Joseph
Lo que significa ser madre
Novedades
9 diciembre, 2018 / NOVEDADES
En los últimos años, se ha comprobado que la conservación de células madre del cordón umbilical es de gran utilidad...
Lea más
4 noviembre, 2018 / NOVEDADES
La enfermedad de Dupuytren consiste en la formación espontánea de queloides o fibrosis en las manos y provoca el cierre...
Lea más
4 noviembre, 2018 / NOVEDADES
Un consorcio español de investigadores liderado por la Universidad Complutense de Madrid (UCM) ha utilizado células madre mesenquimales de la...
Lea más
4 noviembre, 2018 / NOVEDADES
El proceso biológico natural del embarazo reduce el estrés en la mujer, al desactivar la hormona cortisol, y aumenta la...
Lea más
4 noviembre, 2018 / NOVEDADES
El bebé realiza su primer paseo cuando sale de la maternidad hacia su casa. Salvo que el pediatra indique lo...
Lea más
4 noviembre, 2018 / NOVEDADES
Según un estudio del IRB Barcelona publicado en Cell Stem Cell, cuando éstas no están las células madre desaparecen. Cluster...
Lea más
4 noviembre, 2018 / NOVEDADES
La fuerza de las proteínas en el embarazoSi hay algo de lo que tú y tu bebé no podéis prescindir...
Lea más
4 noviembre, 2018 / NOVEDADES
Una investigadora de la Universidad de Coimbra (Portugal), Liliana Mendonça, desarrollará durante el próximo año un proyecto para frenar la...
Lea más
3 octubre, 2018 / NOVEDADES
Una investigadora de la Universidad de Coimbra (Portugal), Liliana Mendonça, desarrollará durante el próximo año un proyecto para frenar la...
Lea más
3 octubre, 2018 / NOVEDADES
Enseñarás a volar, pero no volarán tu vuelo. Enseñarás a soñar, pero no soñarán tu sueño. Enseñarás a vivir, pero...
Lea más